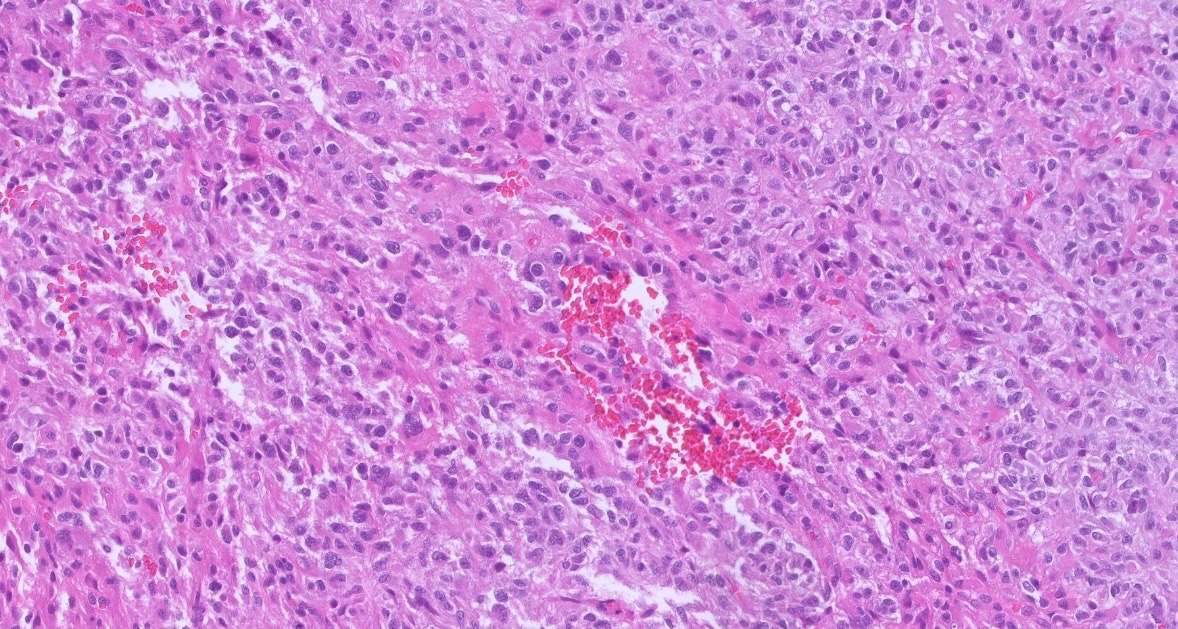
AANP tweet media

The @neuropathology poster walk at #USCAP2026 was a great success! It was wonderful to see all of the #neuropath representation and connect with colleagues.




English
AANP
1.8K posts

@neuropathology
The official X account of the American Association of Neuropathologists (AANP)